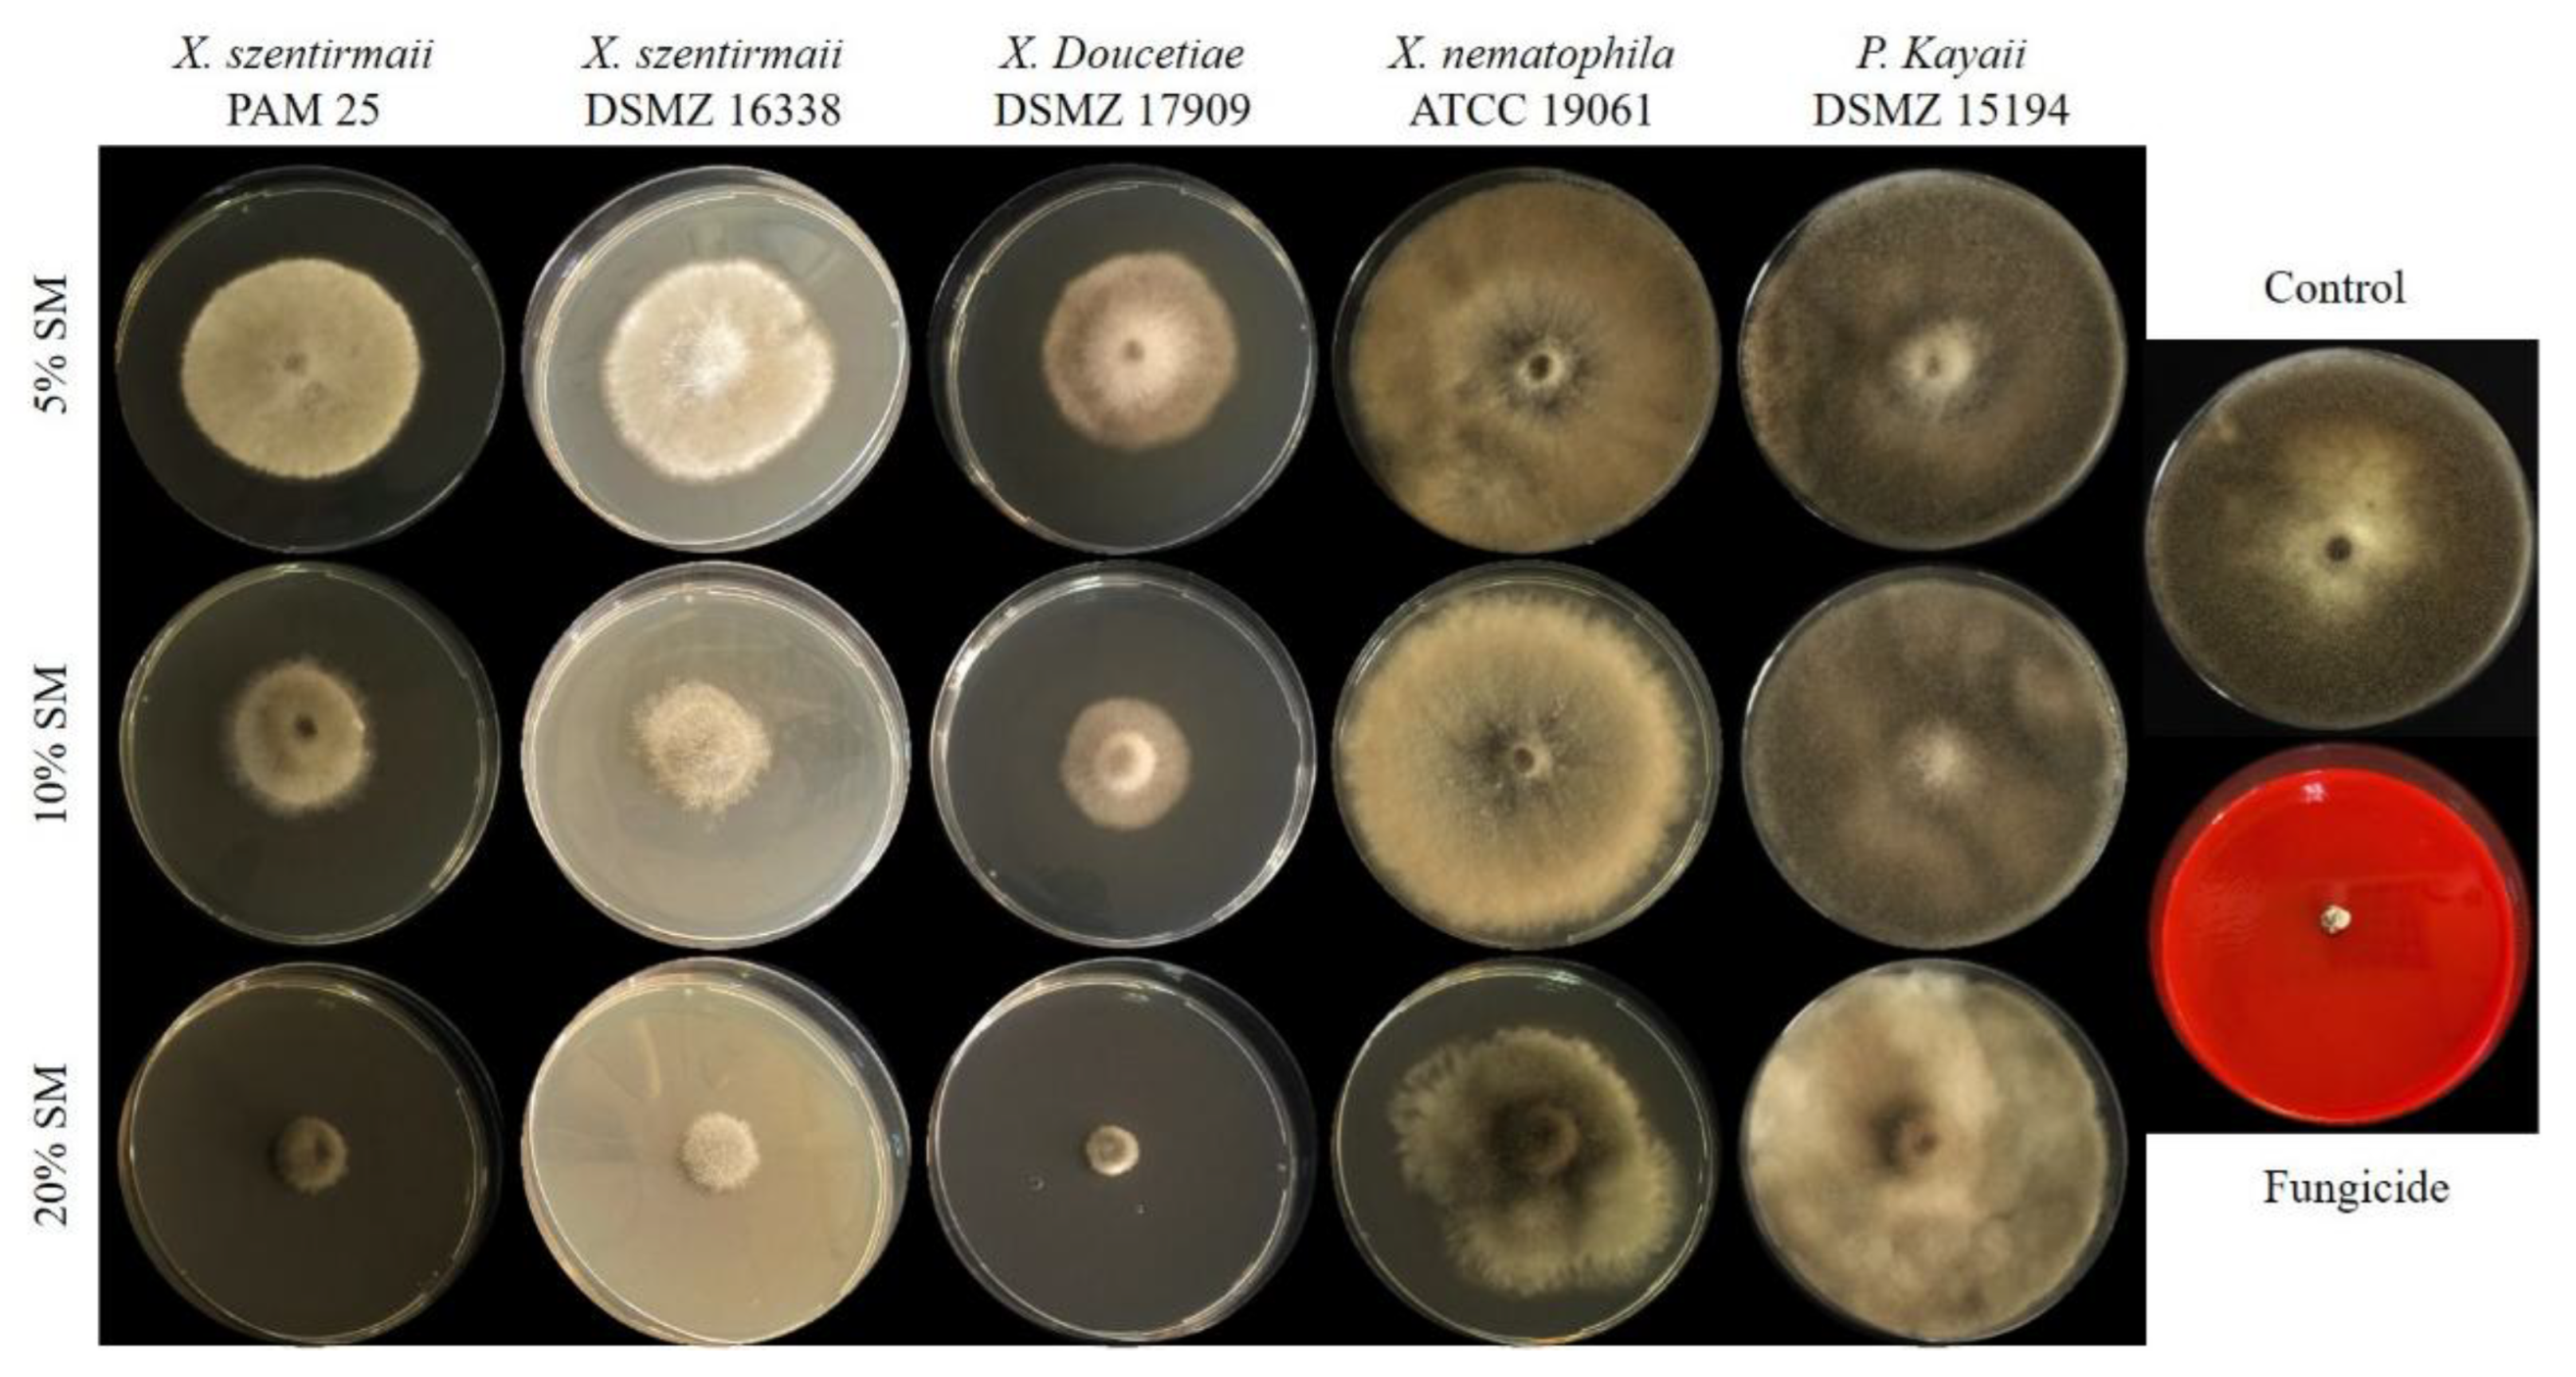
Preprints 174130 g003
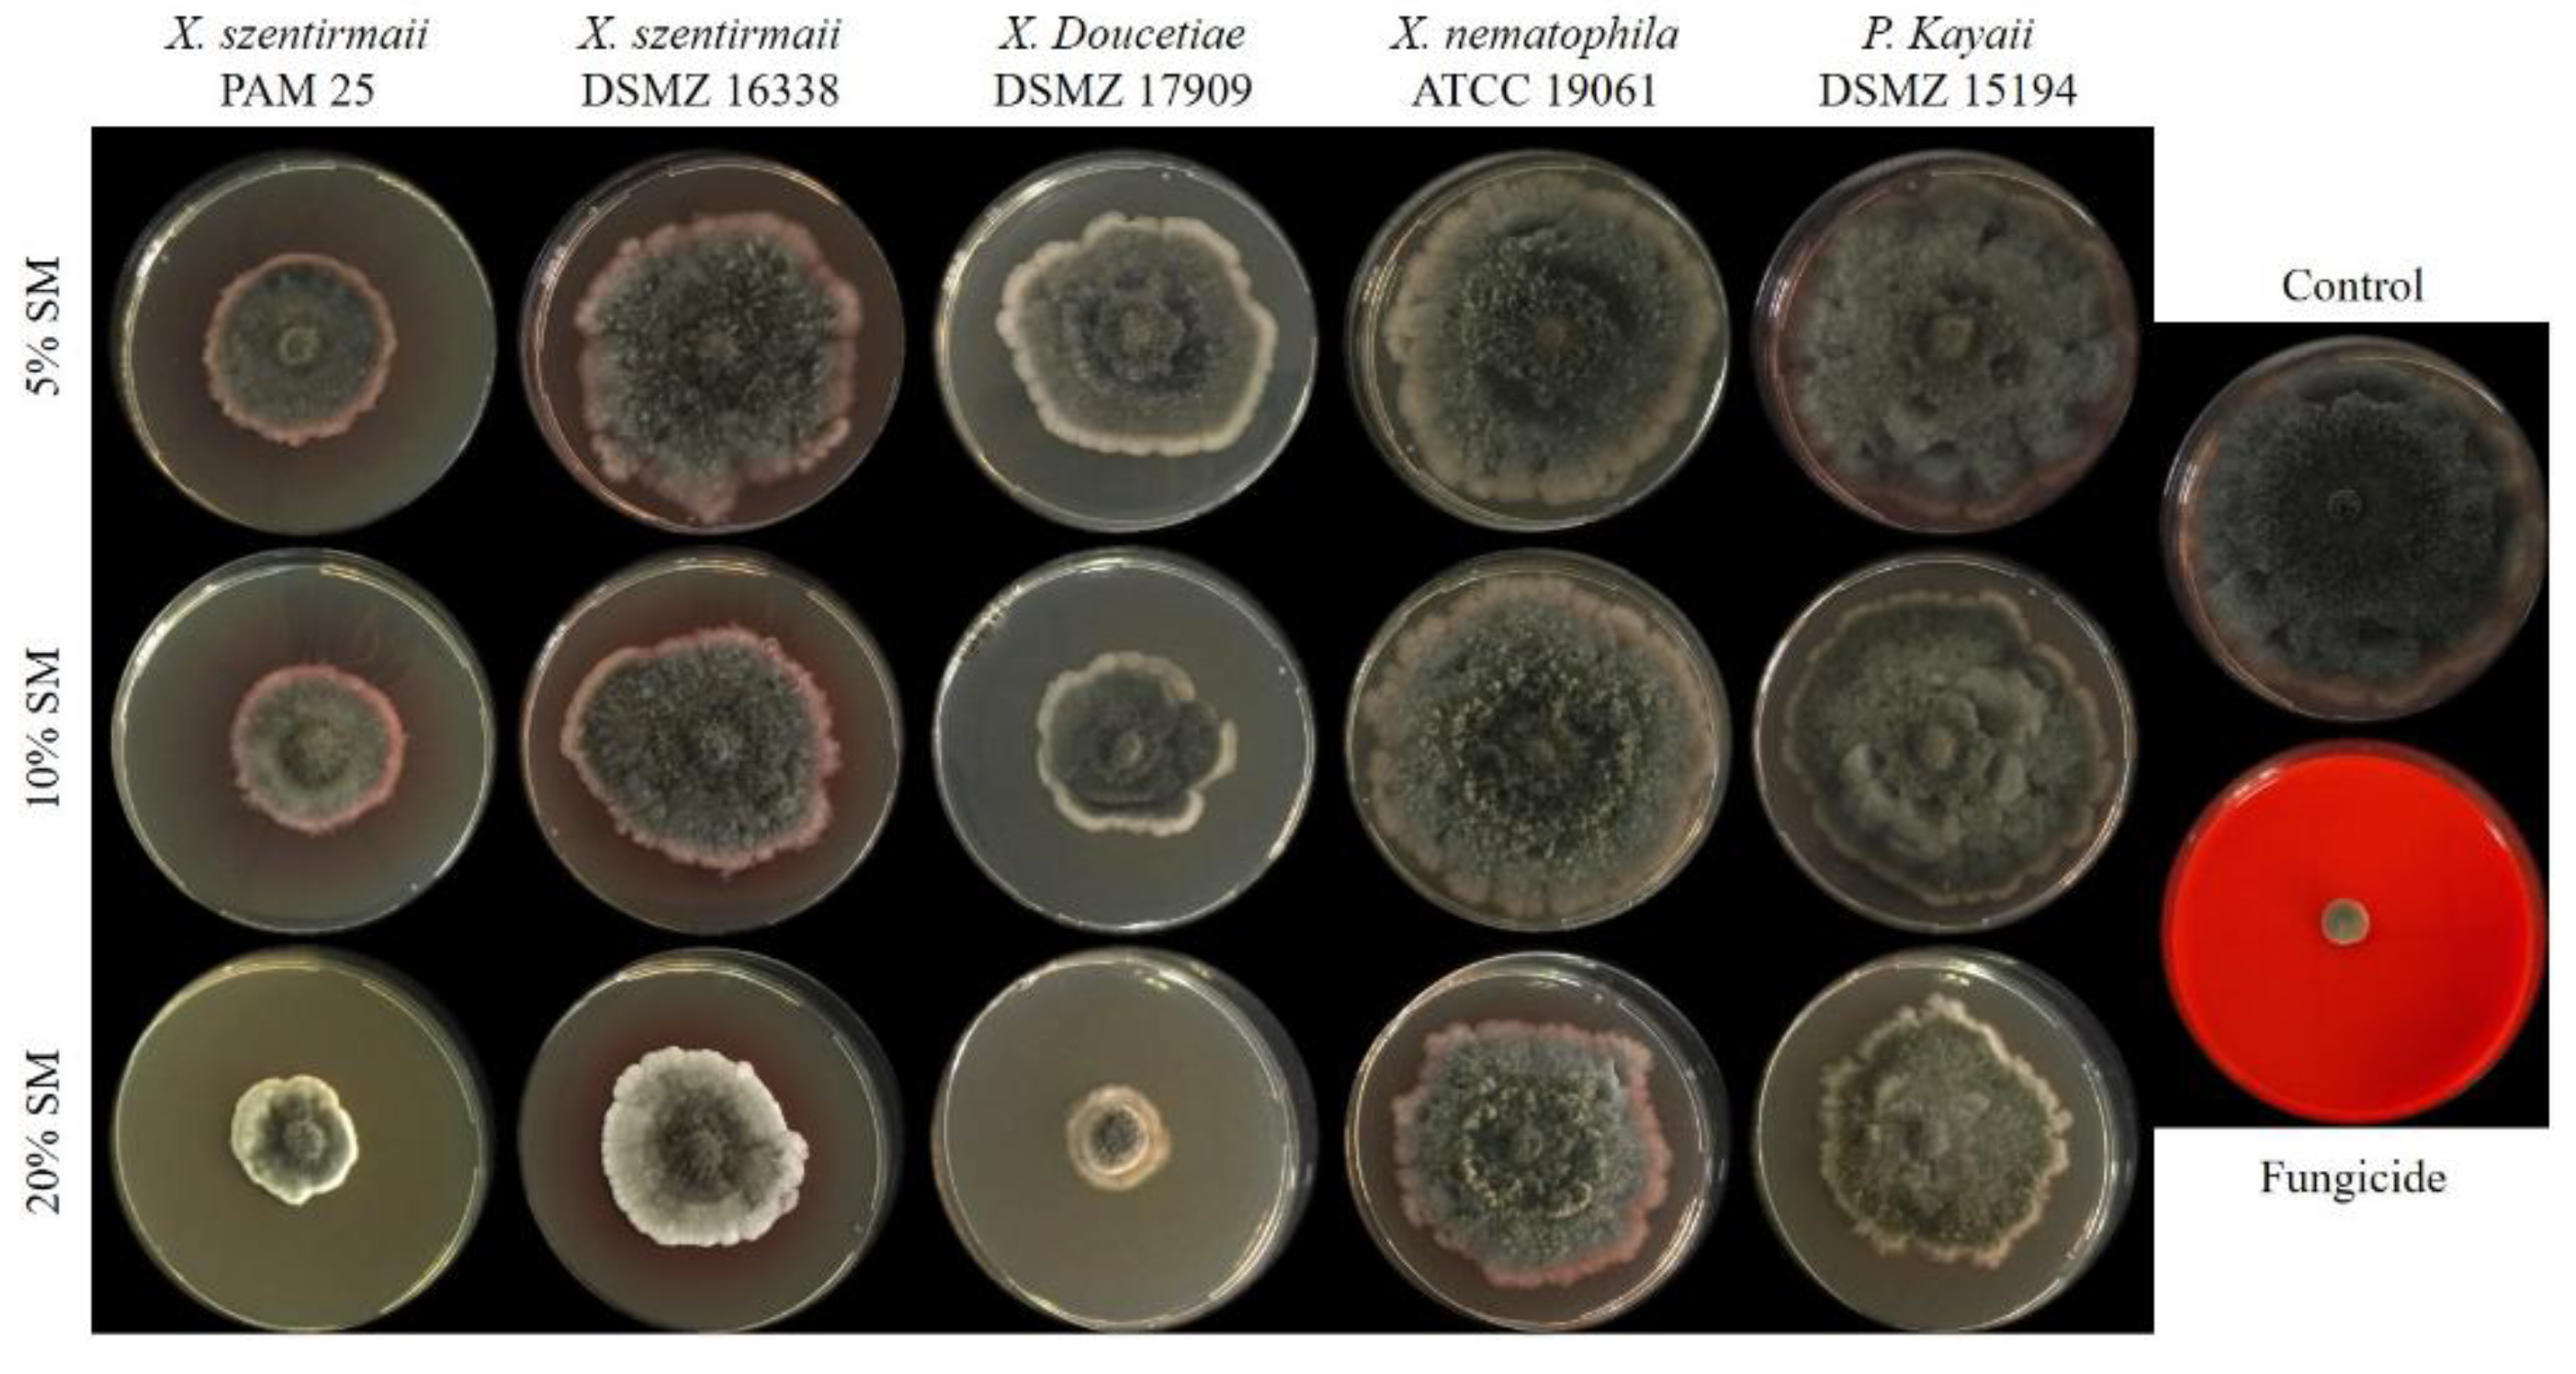
Preprints 174130 g004
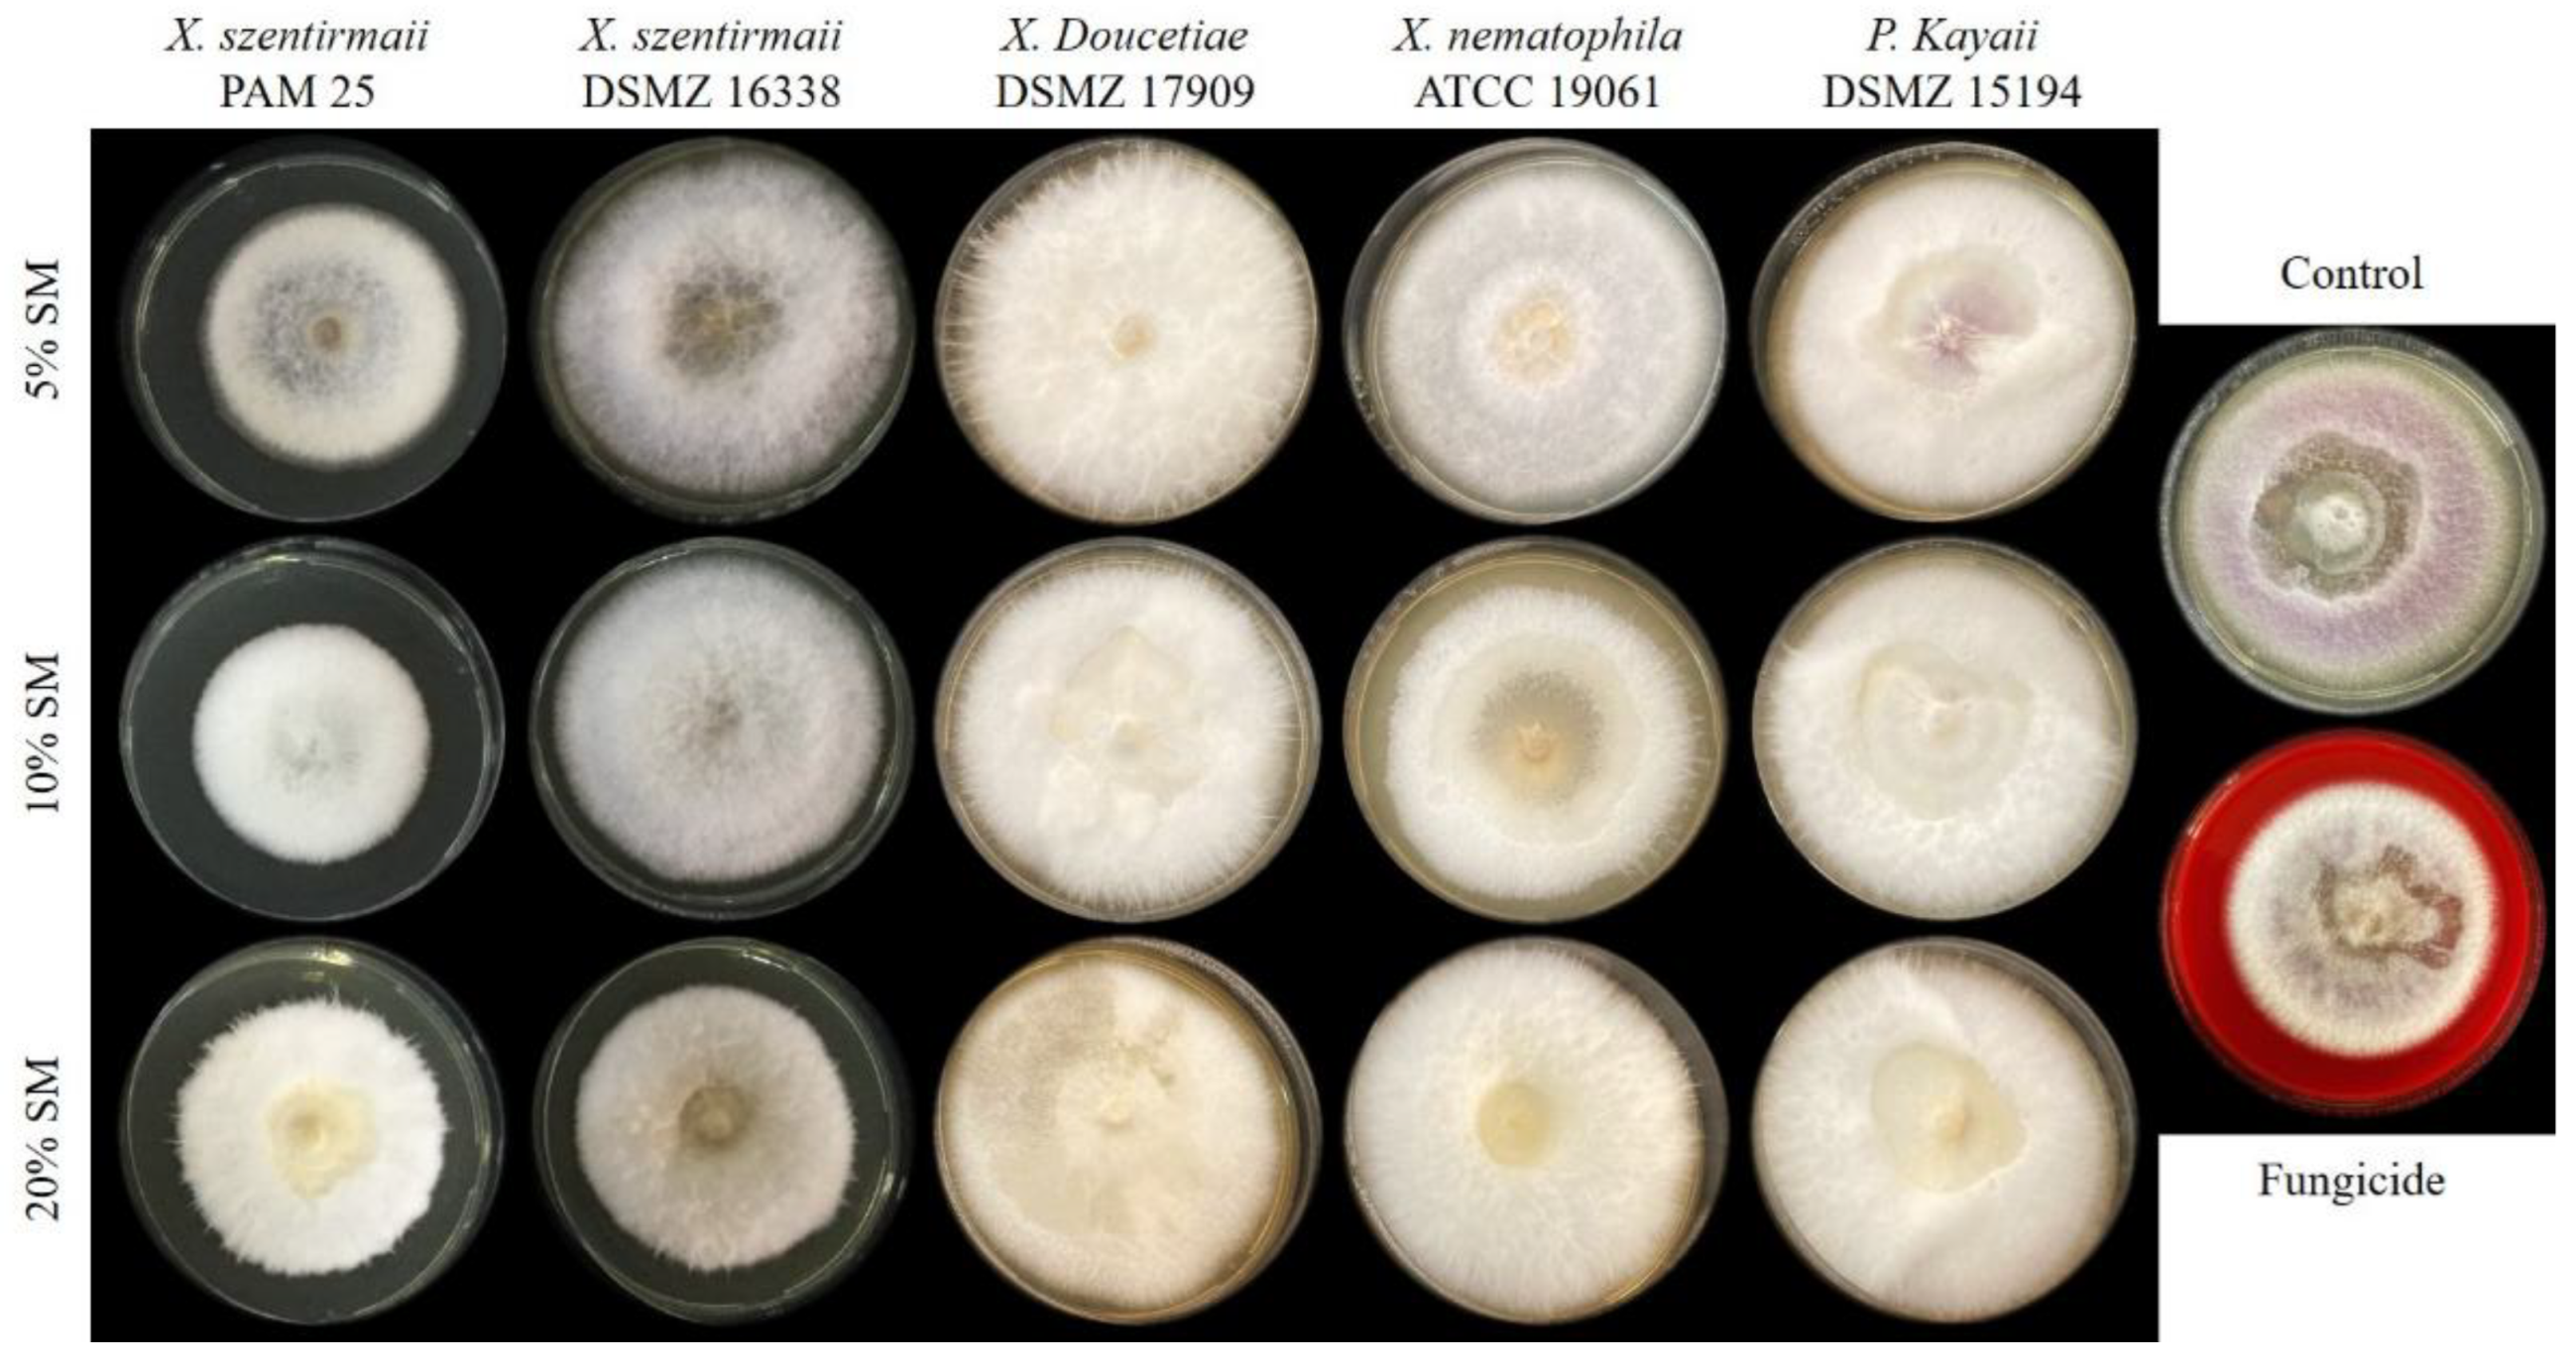
Preprints 174130 g005

1. Introduction
Biotic stressors, particularly phytopathogenic fungi and oomycetes, continue to pose a significant threat to agriculture and forestry. These pathogens induce persistent crop and tree epidemics, resulting in substantial yield losses, estimated between 10-30%, and billions of dollars in annual economic losses (1, 2). Recent years have witnessed an alarming increase in the severity of disease outbreaks attributed to virulent oomycete and fungal pathogens. These organisms negatively impact global food security (3, 4).
Notably, soybeans (Glycine max, Fam: Leguminosae), a crucial industrial crop valued for its high protein and oil content, are susceptible to several soil-borne fungi, including Fusarium, Macrophomina, and Sclerotinia. These pathogens, prevalent in leading soybean-producing regions like Brazil, cause significant damage through seedling blight, seed decay, root and stem rot, charcoal rot, and blight or wilt (5,6,7). Furthermore, these fungi exhibit the capacity to persist in soil, infect plant tissues, and colonize crop residues, with their prevalence influenced by plant physiological state and environmental condition (1, 8, 9). Management strategies for fungal pathogens encompass a range of approaches, including the use of resistant varieties, environmental sanitation, application of chemical pesticides, and utilization of fungal antagonists. While chemical pesticides offer short-term efficacy, their long-term use is associated with detrimental consequences, such as the development of pathogen resistance and environmental toxicity (10, 3, 9). Consequently, there is a pressing need for the development of novel antifungal agents to replace or complement existing control measures.
Ecosystems are characterized by diverse life forms, from microscopic viruses to complex organisms, engaged in intricate relationships that range from mutually beneficial partnerships to exploitative parasitism (11, 12). These symbiotic associations offer significant potential for addressing challenges across various fields, particularly in disease treatment, where they can inspire the development of alternatives to synthetic chemicals (13, 14). A key aspect of these interactions is the production of specialized metabolites by microbes, which mediate their interactions with other organisms. These molecules function as defensive or offensive weapons in microbial competition and defense. Notably, several of these natural products (NPs) show promise as therapeutic compounds or templates for designing novel structural scaffolds (13, 14).
The bacterial genera Photorhabdus and Xenorhabdus are established sources of novel natural products that have anti-fungal, anti-bacterial, or insecticidal properties (15, 16, 36, 42, 43, 45 59). These bacteria are associated with entomopathogenic Heterorhabditis and Steinernema spp. nematodes, found in soil and have a significant potential as biological control agents of agricultural and public health pests (17, 18). This nematode-bacteria symbiosis targets the hemolymph of insect hosts, resulting in the production of a diverse array of secondary metabolites. These metabolites play crucial roles in suppressing insect immunity, defending against competitors, and deterring natural enemies (15, 19). Currently, Xenorhabdus is classified into 32 distinct taxa, with 31 recognized species and one species divided into two subspecies. Similarly, Photorhabdus encompasses 30 taxa, consisting of 23 species and six species that are further subdivided into subspecies (20). Numerous studies have demonstrated the antifungal activity of metabolites in supernatants or extracts produced by these bacteria against various phytopathogenic fungi (21, 22, 25, 26, 27, 28, 29, 30, 32). Genomes of these bacteria contain an impressive number of biosynthetic gene clusters (BGCs) associated with specialized metabolite production (33, 34) and mainly encoding non-ribosomal peptide synthetases (NRPS) and hybrids of NRPS and polyketide synthases (PKS) (34). Several bioactive compounds with antifungal properties have been identified, including xenocoumacin 1 (Xcn1), cabanillasin, and fabclavines from Xenorhabdus species (35, 40, 41, 55), and trans-cinnamic acid (TCA) and benzaldehyde from Photorhabdus species (21, 37). While research has focused on a few species, exploring the metabolic potential of the remaining species and subspecies within both genera could reveal novel bioactive compounds.
This study aimed to: i) evaluate inhibitory effects of cell free supernatants (CFS) from four symbiotic bacteria, including a local isolate (X. szentirmaii PAM 25), against four phytopathogenic fungi; ii) identify the antifungal bioactive compounds produced by mutant strains of X. szentirmaii and X. doucetiae, which were generated by easyPACId (Easy Promoter Activated Compound Identification) approach (44) ; iii) evaluate the shelf stability of X. szentirmaii PAM 25 bacterial liquid culture and its secondary metabolites; and iv) assess the efficiency of X. szentirmaii PAM 25 liquid culture and its metabolites in protecting soybean seeds (BMX Potência cultivar) against Sclerotinia sclerotiorum. This study expands upon previous work by combining the evaluation of various bacterial strains, identifying specific bioactive compounds, and assessing their shelf stability and seed treatment efficacy.
2. Results
2.1. Antifungal activity of cell-free supernatants of wildtype Xenorhabdus spp. and Photorhabdus spp.
A dose dependent effect of cell-free supernatants of Xenorhabdus spp. and Photorhabdus spp. was observed against four phytopathogenic fungi. Across all tested fungi except Fusarium, the fungicide treatment consistently resulted in the highest mycelial inhibition, approaching 100%. However, the level of inhibition induced by the bacterial supernatants varied significantly among the different fungal species.
Against
S. sclerotiorum, at 5% supernatant concentration,
X. szentirmaii PAM 25 and DSM 16338 strains demonstrated the highest inhibition rates of 25.28 and 30.54%, respectively, whereas
P. kayaii and
X. nematophila exhibited the least efficacy (P<0.05). There was a significant difference among the bacteria species (F = 317.62; df = 6, 133; P < 0.0001) (
Figure 1A,
Figure 2).
The percentage mycelial inhibition increased as the concentration of the supernatant increased from 5% to 20%. At 20%,
X. szentirmaii DSM 16338 and PAM 25 show the most promising antifungal activity, with nearly 100% inhibition at 20% concentration, followed by
X. doucetiae with 87% inhibition. There were no significant differences among these three bacterial strains. In contrast
P. kayaii and
X. nematophila presented relatively lower inhibition ranging between 24-27% (F = 559.14; df = 6, 133; P < 0.0001) (
Figure 1A).
Similarly, at 5% concentration,
X. szentirmaii DSM 16338 showed a significant
B. cinerea mycelial inhibition of 71.89%, followed by PAM 25 with 56.37% (F = 942.29; df = 6, 133; P < 0.0001) (
Figure 1B,
Figure 3).
Xenorhabdus nematophila and
P. kayaii exhibited considerably lower mycelial inhibition against
B. cinerea across all tested concentrations compared to the other bacterial supernatants. Among the bacterial supernatants at a 10% concentration,
X. szentirmaii DSM 16338 exhibited the highest mycelial inhibition at 94.32%, followed by
X. doucetiae which demonstrated significant inhibition at 83.52%.
Xenorhabdus szentirmaii PAM 25 strain showed a moderate level of inhibition at 69.90% (F = 1227.48; df = 6, 133; P < 0.0001). At 20%, both
X. szentirmaii strains and
X. doucetiae demonstrated the highest inhibition among the bacterial supernatants, reaching over 96.53% against
B. cinerea.
Photorhabdus kayaii showed the lowest inhibition, with only 16.82% at the highest concentration (20%) (F = 1123.13; df = 6, 133; P < 0.0001) (
Figure 1B).
Macrophomina phaseolina demonstrated the highest susceptibility to the bacterial treatments. Mycelial inhibition induced by the bacterial supernatants generally increased with increasing supernatant concentration. At 5% concentration,
X. szentirmaii DSM 16338 and PAM 25 strains demonstrated 88.19% and 71.83%. inhibition, respectively.
Xenorhabdus nematophila and
X. doucetiae showed limited antifungal activity. There was a significant difference among the bacteria species (F = 1245.23; df = 6, 133; P < 0.0001) (
Figure 1C,
Figure 4).
Xenorhabdus doucetiae showed moderate inhibition (71.16%) at 10% and high inhibition (94.83%) at 20%. In contrast,
P. kayaii and
X. nematophila displayed significantly lower mycelial inhibition across all tested concentrations compared to the other tested bacteria (P<0.05). At 20%,
X. szentirmaii DSM 16338 and
X.
doucetiae were the most effective, achieving high levels of inhibition (over 90%) followed by
X. szentirmaii PAM 25 strain with 86% inhibition (F = 269.75; df = 6, 133; P < 0.0001) (
Figure 1C).
Fusarium oxysporum generally showed lower levels of inhibition.
Xenorhabdus szentirmaii DSM 16338 was the most effective bacterial supernatant at lower concentrations (5% and 10%), exhibiting mycelial inhibition of 52.43% and 64.66%, respectively. Following this,
X. szentirmaii PAM presented 33-48% fungal inhibition at lower concentrations (5% and 10%). There was a significant difference among the bacteria species (at 5% F = 429.50; df = 6, 133; P < 0.0001 and at 10% F = 346.32; df = 6, 133; P < 0.0001) (Fig 1D, Fig 5). At 20% (F = 204.06; df = 6, 133; P < 0.0001),
X. szentirmaii DSM 16338 efficacy decreased to 41.32%, whereas
X. szentirmaii PAM 25 demonstrated the highest inhibition (59.14%) among the bacterial treatments, even surpassing the fungicide's effect (37.42%).
Xenorhabdus doucetiae displayed relatively low inhibition at 5% (3.99%), which gradually increased to moderate levels at 10% (7.38%) and 20% (12.19%). In contrast,
X. nematophila and
P. kayaii exhibited minimal inhibitory effects against
F. oxysporum across all tested concentrations (
Figure 1D,
Figure 5).
2.2. Antifungal Compounds Produced by Xenorhabdus szentirmaii and X. doucetiae
Among the 8 compounds generated by
X. szentirmaii mutants, CFS of Δ
hfq LP-56 mutants producing fabclavine provided the highest inhibition of the three fungi
S. sclerotiorum (F = 572.92; df = 12, 259; P < 0.0001),
B. cinerea (F = 203.07; df = 12, 259; P < 0.0001), and
M. phaseolina (F=5187.99; df=11,239, P< 0.0001), with > 90% inhibition. Antifungal inhibition rate of this CFS against
F. oxysporum was 75.6% (F =1153.92; df = 12, 259; P < 0.0001) (
Figure 6). There was no significant difference between CFS of wild type and Δ
hfq LP-56 mutants against
S. sclerotiorum and
B. cinerea. Fabclavine was the sole metabolite to significantly inhibit
M. phaseolina and
F. oxysporum, achieving over 70.0% inhibition, which significantly differed from the positive control (WT
X. szentirmaii DSM 16338) (P<0.001) (
Figure 6). Against
M. phaseolina and
F. oxysporum, most compounds showed limited inhibitory activity, with significant inhibition observed only for the positive control (
X. szentirmaii DSM 16338) and fabclavine (
Figure 6).
Besides fabclavine, pyrollizixenamide and szentirazine inhibited
S. sclerotiorum mycelial growth by 60.3% and 28.8%, respectively (
Figure 6) whereas, rhabdopeptid, pyrollizixenamide, and xenobactin inhibited
B. cinerea mycelial growth by less than 50%, significantly differing from the other compounds (P<0.0001) but not from each other (P=0.372).
For
X. doucetiae, four secondary metabolites were tested. Xenocoumacins significantly inhibited
S. sclerotiorum (F = 173.988; df = 5, 119; P < 0.0001) and
M. phaseolina (F = 740.804; df = 5, 119; P < 0.0001), achieving inhibition rates above 85.0%. This inhibition differed significantly from that of the other compounds but not from the positive control (
X. doucetiae wild type) (Figures 7A and 7C). All tested SMs produced by
X. doucetiae (xenorhabdin, phenylethylamides, tryptamides and xenocoumacin) inhibited
B. cinerea mycelial growth by 38.7% to 59.1%, significantly lower than the
X. doucetiae wild type, which inhibited 98.5% (F = 46.956; df = 5, 119; P < 0.0001) (
Figure 7B). Against
F. oxysporum, all tested compounds showed minimal inhibitory activity, ranging from 0.35% to 1.02%, whereas
X. doucetiae wild type inhibited only 8.7%, significantly differing from the
X. doucetiae mutants (F = 27.555; df = 5, 119; P < 0.0001) (
Figure 7D).
2.3. Shelf stability of Xenorhabdus szentirmaii secondary metabolites
Xenorhabdus szentirmaii PAM 25 supernatant provided > 80% inhibition of
S. sclerotiorum growth throughout the storage period (360 days) at all three tested temperatures (
Table 1).
2.4. Efficacy of Xenorhabdus szentirmaii broth culture and its cell-free supernatant for soybean seed protection
The broth culture and cell-free supernatant of
X. szentirmaii PAM 25, both diluted at 10% and undiluted, were effective in inhibiting
S. sclerotiorum in seed treatments, ensuring ≥80% seed germination, with no significant difference compared to the fungicide treatment (thiophanate-methyl + fluazinam) (
Figure 8). Forty to 54% of soybean seeds in
Trichoderma asperellum-treated-group germinated, demonstrating
Trichoderma’s low efficacy against
S. sclerotiorum in seed protection and its negative effect on seed viability. There was a significant difference between the treatments (F = 4.486; df = 7, 56; P < 0.0005) (
Figure 8).
3. Discussion
This study evaluated the antifungal potential of cell-free supernatants from four symbiotic bacteria, including a local isolate, X. szentirmaii PAM 25, against four phytopathogenic fungi. Furthermore, it assessed the efficacy of X. szentirmaii PAM 25 and its metabolites in protecting soybean seeds from S. sclerotiorum and investigated the shelf stability and seed treatment effects of these bacterial metabolites.
Among the isolates tested, X. szentirmaii DSM 16338, X. szentirmaii PAM 25, and X. doucetiae demonstrated significant inhibition (>90%) against S. sclerotiorum, B. cinerea, and M. phaseolina, exhibiting superior efficacy compared to X. nematophila and P. kayaii. Consistent with numerous reports highlighting the antifungal activity of bacterial metabolites against various phytopathogens. Cell-free supernatants from bacteria species, including X. khoisanae, X. nematophila, X. szentirmaii, P. kayaii, P. laumondii, and P. temperata have shown substantial inhibition of mycelial growth in a wide range of fungi, such as Fusicladium carpophilum, F. effusum, Armillaria tabescens, Botrytis cinerea, Fusarium oxysporum, Fusarium solani, Phytophthora capsica, Rhizoctonia solani, S. sclerotiorum, and Neofusicoccum parvum, Colletotrichum gloeosporioides (21, 22, 23, 24, 25, 26, 27, 28, 29, 30, 31, 32, 46, 56). Generally, Xenorhabdus species exhibited greater antifungal activity compared to Photorhabdus species, and fungal susceptibility to bacterial metabolites varied. Botrytis cinerea proved particularly susceptible, with a 10% concentration of X. szentirmaii DSM 16338 inhibiting 94.3% of its mycelial growth. This finding aligns with previous studies that reported >90% inhibition of B. cinerea using 10% Xenorhabdus spp. supernatant (25, 26, 46). However, contrasting results were observed with P. kayaii and X. nematophila. At 20% concentration, these isolates inhibited only 16.8% and 3.6% of B. cinerea mycelial growth, respectively. This contradicts a previous study by (25) which reported >90% inhibition of B. cinerea and Phytophthora capsici in vitro using a 10% X. nematophila supernatant. This difference may be due to the different isolates used in the studies.
Fusarium oxysporum demonstrated greater resistance to the bacterial supernatant. Specifically, X. szentirmaii PAM 25 supernatant at 20% concentration inhibited 59% of fungal mycelial growth, while X. szentirmaii DSM 16338 achieved 64.7% inhibition at 10% and 52.4% at 5% concentration. These results are consistent with previous findings, where Xenorhabdus species inhibited F. oxysporum growth by 49% and 70% in studies by Vanitha et al. (47) and Lalramchuani et al. (48), respectively. However, the supernatants of X. szentirmaii DSM 16338, X. szentirmaii PAM 25, and X. doucetiae effectively inhibited Macrophomina phaseolina mycelial growth, achieving ≥80% inhibition at 20% concentration and >70% at 10% concentration. This aligns with Sharma et al. (49), who reported that Xenorhabdus assam-isolate (Sg as1) metabolites, extracted with ethyl acetate and applied at 1000 µg/mL, exhibited significant antifungal activity against M. phaseolina (EC50 = 55.98 µg/mL), resulting in 70% mycelial inhibition.
Following the evaluation of cell-free supernatants, this study further sought to identify the specific antifungal bioactive compounds produced by mutant strains of X. szentirmaii and X. doucetiae, which were generated easyPACId approach. Fabclavines from X. szentirmaii showed broad-spectrum activity against all four tested fungi (>76%). Xenocoumacin from X. doucetiae inhibited S. sclerotiorum and M. phaseolina with inhibition rates above 85.0%, and B. cinerea at 38.7% to 45.0%. However, xenocoumacin was ineffective against F. oxysporum. Both fabclavines and xenocoumacins are hybrid hexapeptide/polyketide water-soluble peptides synthesized by non-ribosomal peptide synthetases (NRPS) and polyketide synthases (PKS) enzyme systems (44, 50, 51). These compounds have various biological activities including antibacterial and antifungal activities playing key roles in inhibiting saprophytic and competitive organisms to infect insect hosts (51, 52). The complex structures of fabclavines and xenocoumacins suggest that they may interact with multiple cellular targets, contributing to their observed antifungal activity. While precise mechanisms are still under investigation, potential pathways include: disruption of fungal cell membrane integrity leading to leakage and interference with essential transport processes for fabclavines (51), and inhibition of protein translation and cell wall component synthesis for xenocoumacins (53, 54). Different Xenorhabdus species produce a range of fabclavine and xenocoumacin derivatives, exhibiting substantial structural and bioactivity variations (50,51). Xenorhabdus doucetiae does not possess harbor the biosynthesis gene cluster involved in fabclavine production (44). Beyond their antifungal activity, both fabclavine and xenocoumacin have been established to have great potential in pathogen treatment and pest control (39, 43, 52, 57, 58). Sharma et al. (50) reported strong antifungal activity from ethyl acetate extracts of X. assam (Sg as1) filtrates against M. phaseolina, detecting xenocoumacin, xenorhabdin, and nematophin as the three main antifungal compounds. In this study, the three compounds were evaluated separately, with xenocoumacin exhibiting the highest antifungal activity.
Pyrollizixenamide and szentirazine produced by X. szentirmaii also exhibited antifungal effects against S. sclerotiorum and B. cinerea, ranging between 23.8-60.3%. The other tested compounds showed limited inhibitory activity against these pathogens. Pyrollizixenamide and szentirazine are part of the complex chemical arsenal that Xenorhabdus bacteria use to interact with their environment (44)
This study also investigated the shelf stability and seed treatment effects of these bacterial metabolites. The cell-free supernatant of X. szentirmaii PAM 25 exhibited >94.0% inhibition of S. sclerotiorum mycelial growth after one year of storage at 25°C. The bacterial culture and supernatants of X. szentirmaii PAM 25 effectively control S. sclerotiorum in soybean seeds, allowing for more than 80% seed germination, demonstrating similar efficacy as the thiophanate-methyl + fluazinam fungicide. This bacterium was more effective than fungal biocontrol product, T. asperellum which exhibited low efficacy against S. sclerotiorum in seed protection and had negative effect on seed viability. Similarly, the antifungal activity of X. szentirmaii bacterial culture and supernatants against Monilinia fructicola remained stable for 9 months when stored at 20°C and 4°C (28). In the case of seed treatments, undiluted and 10% bacterial broth culture and supernatants of X. szentirmaii PAM 25 ensured >80% soybean seed germination in the presence of S. sclerotiorum. In a previous study, 33% diluted X. szentirmaii PAM 25 bacterial culture effectively inhibited S. sclerotiorum on soybean seeds and promoted significant seed germination and plant development (22).
This study highlights the potential of Xenorhabdus species, particularly X. szentirmaii, as effective biological control agents. The identification of fabclavines and xenocoumacins as key antifungal compounds provides valuable insights into the mechanisms of action. Further research could delve deeper into their precise mechanisms of action. Investigating the molecular interactions between these compounds and fungal cells could reveal novel targets for antifungal drug development. The demonstration of shelf stability and seed treatment efficacy underscores the feasibility of direct seed application of Xenorhabdus bacteria. This practical approach offers a safe and novel biological control method, presenting a promising alternative to environmentally harmful chemical fungicides. Future research should focus on conducting field trials to evaluate the efficacy of Xenorhabdus and Photorhabdus bacteria and their metabolites under real-world agricultural conditions, as well as investigating their effects on non-target organisms and soil health.
4. Materials and Methods
4.1. Maintenance of Phytopathogenic Fungal Cultures
Fusarium oxysporum, Botrytis cinerea, and Macrophomina phaseolina fungal isolates were sourced from the Department of Plant Protection, Faculty of Agriculture at Aydin Adnan Menderes University, Türkiye. Sclerotinia sclerotiorum was isolated from soybean plants cultivated in Pilar do Sul, São Paulo (SP), Brazil, and was obtained from the Mycological Collection of the Phytopathology Laboratory at the Instituto Biológico, Campinas-SP, Brazil. Fusarium oxysporum, B. cinerea and M. phaseolina were incubated at 25°C in the dark for 7-14 days prior to use, while S. sclerotiorum was kept at 22°C.
4.2. Xenorhabdus spp. and Photorhabdus spp. sources
The wildtype bacterial strains of
Xenorhabdus spp. and
Photorhabdus spp. were obtained from the American Type Culture Collection or the German Collection of Microorganisms and Cell Culture. These reference strains were sourced from the Invertebrate Animals Laboratory's microorganism collection at Aydin Adnan Menderes University, Türkiye (
Table S1).
Xenorhabdus szentirmaii PAM 25, a Brazilian isolate, was provided by the Biological Pest Control Laboratory at the Instituto Biológico-CAPSA, Campinas-SP, Brazil. All bacteria strains in 50% glycerol solution at -80°C.
4.3. Preparation of bacterial supernatants
The strains of Xenorhabdus spp. and Photorhabdus spp. were subcultured from stock cultures on Luria-Bertani (LB) agar (tryptone 10 g/L, yeast extract 5 g/L, NaCl 5 g/L, agar 15 g/L) and incubated in a BOD incubator at 28°C for 24 hours. Subsequently, a single colony of the respective strain was transferred to a 100 mL Erlenmeyer flask containing 10 mL of LB Broth and incubated at 30°C for 24 hours under constant agitation at 150 rpm. After this period, the cell concentration was determined using a spectrophotometer (OD600=1), and the phase I status of the bacteria was confirmed through isolation on NBTA medium (nutrient agar, bromothymol blue, triphenyl tetrazolium chloride) or the catalase test (38). Five mL samples of the bacterial cultures were inoculated into a 1 L Erlenmeyer flask containing 500 mL of LB medium (1 mL of culture per 100 mL of medium) and incubated at 30°C for 6 days under constant agitation at 150 rpm (60). After this period, the bacterial culture was transferred to 50 mL Falcon tubes and the supernatant was obtained by centrifugation (10,000 rpm, 4°C, 10 min.). The supernatant was filtered through a 0.22 µm cellulose filter and stored at -20 °C for up to two weeks prior to use in the experiments (39).
4.4. Antifungal activity of cell-free supernatants of wildtype Xenorhabdus spp. and Photorhabdus spp.
Obtained cell-free supernatants (CFS) were incorporated into potato dextrose agar (PDA) at 5, 10, and 20% (v/v) concentrations. The bacterial supernatants were added after the autoclaved PDA medium was allowed to cool to 45–50 °C, and the solution was thoroughly mixed before pouring the plates. The positive control consisted of PDA medium plus the fungicide Maxim®XL (active ingredients: Metalaxyl-M + Fludioxonil) at a ratio of 1 mL fungicide per 100 mL medium. In the negative control group, no supernatant was added; instead, sterile LB medium was added to the Petri dishes. The fungal phytopathogens were added to the prepared plates by transferring a 5-mm-diameter mycelia plug from an actively growing fungal culture using a sterile transfer tube on to the center of each Petri dish containing bacterial supernatant, or LB (control) (25). Plates were incubated at 25 °C in darkness, and two perpendicular diameter measurements of fungal growth were taken after 14 days of incubation, and the average was calculated. The colony area was calculated as πr². The area of the 5-mm plug in the middle of the plate was not included in the measurement (28). Each treatment (4 fungi, 5 bacteria, and 3 supernatant concentrations) comprised 10 Petri dishes, and experiments were conducted in triplicate on different dates.
4.5. Determination of Antifungal Bioactive Compounds Produced by X. szentirmaii and X. doucetiae
The generation of mutants was described previously (44). The strains, maintained at the Max Planck Institute for Terrestrial Microbiology in Marburg, Germany, were used in this study, with in summary 10 strains evaluated (
Table 2).
4.6. Determination of bioactive compounds using easyPACId strains
The antifungal bioactive compounds of X. szentirmaii and X. doucetiae easyPACId strains were evaluated against the mycelial growth of S. sclerotiorum, B. cinerea, M. phaseolina, and F. oxysporum. Initially, the mutant strains were cultured in LB agar medium supplemented with 50 μg/mL of kanamycin (final concentration), while the WT, Δhfq and Δpptase control strains were grown in LB medium without kanamycin (39). All strains were incubated at 30°C for 48 hours under agitation at 150 rpm. For the pre-culture, a single colony of each strain was inoculated into 10 mL of LB medium + kanamycin and incubated at 30°C under constant agitation at 150 rpm for 24 hours. Subsequently, the pre-cultures were inoculated into 20 mL of LB medium with an optical density (OD600) adjusted to 0.1 and incubated at 30°C for 1 hour. Afterwards, the cultures were induced with 0.2% L-arabinose and incubated for 72 hours at 30°C under agitation at 150 rpm (39). Subsequently, the bacterial culture was transferred to 50 mL Falcon tubes and centrifuged at 10.000 rpm, 4°C for 10 mins. The supernatant was filtered through a 0.22 µm cellulose filter and stored at -20 °C for up to 2 weeks prior to use in the experiments (39).
Cell-free supernatants from 10 strains (
Table 2) were prepared and incorporated into PDA medium at a concentration of 20%. The experimental design and number of replicates per treatment were identical to the previous assay. The controls included the wild type X. szentirmaii and X. doucetiae as well as the respective Δhfq strains, while the negative control was PDA medium. Each treatment had 10 replicates, and the experiments were conducted three times.
4.7. Shelf stability of X. szentirmaii secondary metabolites
The study assessed the shelf stability of X. szentirmaii PAM 25 secondary metabolites. This is a crucial point for developing practical applications, as stability is essential for commercial products. X. szentirmaii PAM 25 was grown in LB medium, maintained at 27°C for 6 days under constant agitation at 150 rpm. Afterwards, the culture was centrifuged to obtain cell-free supernatants (CFS) as described previously.
A 25 mL aliquot of CFS including secondary metabolites was transferred to separate 100 mL Schott bottles and stored at three different temperatures: 5ºC, 25ºC, and 35ºC. The contents of the bottles were evaluated at the following time points: 0, 7, 15, 30, 60, 90, 120, 150, 180, 210, 240, 270, 300, 330, and 360 days. One bottle was prepared for each temperature and storage time. At each time point, the CFS from each temperature were added to PDA medium at a 10% ratio. For control, only LB medium was added. A 5 mm diameter disc of S. sclerotiorum mycelial culture was inoculated in the center of each plate (28). Sixteen replicates were established for each treatment, each replicate represented by 100 mL Schott bottle.
The evaluated parameter was fungal inhibition, measured as the colony diameter (cm) in the medium until the control treatment (PDA) reached the full diameter of the plate. The experiment was concluded when the metabolites caused ≥50% inhibition to the mycelial growth.
The percentage inhibition of S. sclerotiorum mycelial growth for each treatment was compared to the control treatment using the following formula (Dc - Dt) / Dc × 100%, where Dc and Dt represent the colony diameters of the control and treatment, respectively.
4.8. Efficacy of X. szentirmaii broth culture and its cell-free supernatant in soybean seed protection
This study evaluated the efficiency of X. szentirmaii PAM 25 metabolites in protecting soybean seeds (BMX Potência cultivar) against S. sclerotiorum. This aims to demonstrate the potential of these bacteria and their secondary metabolites for agricultural applications.
Xenorhabdus szentirmaii PAM 25, which showed the highest inhibition rate in the first experiment, was cultivated in an Erlenmeyer flask containing 300 mL of LB medium, maintained at 27°C for 6 days under constant agitation at 150 rpm. The bacterial broth culture was divided into two parts and one part was centrifuged at 10.000 rpm for 10 mins and filtered to obtain cell-free supernatant as described in the previous experiment.
Six treatments were established, including:
Cell-free Supernatant at 10%
Bacterial liquid culture at 10%
LB medium (negative control)
Distilled water (negative control)
CERTEZA® fungicide (a.i. Tiafanato metilico+fluazinam; dose 56.0 µL/28.0 g of seeds) (positive control)
TrichoTurbo® biofungicide (a.i. Trichoderma asperellum BV10; dose 4 mL/kg of seeds) (positive control)
For adherence to the seeds, treatments containing bacterial broth culture or CFS and TrichoTurbo® were supplemented with 1% xanthan gum.
The soybean seeds superficially disinfected with 2% sodium hypochlorite were placed in an autoclaved plastic bag. After adding the treatment materials, the bags were shaked vigorously for 3 minutes. The treated 10 seeds were placed in Petri dishes (90 x 15 mm) containing filter paper moistened with autoclaved distilled water. For treatments involving the phytopathogenic fungus, a 5 mm diameter disc of S. sclerotiorum mycelial culture (grown for 10 days on PDA at 20ºC in darkness) was placed over the hilum of the treated seeds. The Petri dishes were sealed with PVC film and maintained at 25°C in darkness for 7–14 days. Each treatment had four replicates, with each replicate represented by one Petri dish. This experiment was conducted twice.
Seeds infected with Sclerotinia do not germinate or germinate poorly compared to healthy seeds. The evaluation consisted of counting the number of germinated seeds 10 days after the experiment setup. The data were expressed as the percentage of germinated seeds.
4.9. Data analysis
The inhibition percentage data were transformed using the arcsin √(x/100) function, where x represents the percentage of each treatment’s replicate. The data on mycelial growth area were analyzed using ANOVA. Treatment means were compared using Tukey's test at a 5% significance level. Statistical analyses were performed using SPSS version 23 and SISVAR DEX/UFLA, version 5.6.
Supplementary Materials
The following supporting information can be downloaded at the website of this paper posted on Preprints.org: Table S1: Symbiotic bacteria evaluated with their respective entomopathogenic nematodes.
Author Contributions
Funding Acquisition, S.H., J.G.C-O. and L.G.L.; Resources, S.H., J.G.C-O. and L.G.L.; Methodology, S.H., C.J.B., and L.G.L.; Investigation, N.O-M.; Validation, N.O-M., S.H., J.G.C-O., C.J.B., and L.G.L.; Formal Analysis, N.O-M., M.T., H.C., E.B., H.B.B., and C.J.B.; Visualization, N.O-M., M.T., H.C., S.H., C.J.B., and L.G.L.; Data Curation, M.T., H.C., E.B., H.B.B., S.H., J.G.C-O., C.J.B., and L.G.L.; Conceptualization, S.H., C.J.B., and L.G.L.; Project Administration, S.H., J.G.C-O., and L.G.L.; Supervision, S.H., C.J.B., and L.G.L.; Writing – Original Draft Preparation, N.O-M., M.T., H.C., S.H., and L.G.L.; Writing – Review & Editing, All the authors. All authors have read and agreed to the published version of the manuscript. .
Funding
This study was supported by the Max Planck Society (for HBB), the Aydin Adnan Menderes University (Project No. 22014), the São Paulo State Research Foundation – FAPESP (Project Nos. 2017/50334-3, 2019/23702-7, and 2021/11945-2), and the CNPq/INCT Innovative Bioinputs (Project No. 406803/2022-6).
Institutional Review Board Statement
Not applicable.
Informed Consent Statement
Not applicable.
Data Availability Statement
All data generated or analyzed during this study are included in this published article. Any other information is available from the corresponding author on upon request.
Acknowledgments
We would like to thank Dr. Silvânia Helena Furlan who provided the soybean seeds of the BMX Potência RR cultivar obtained from BASF®.
Conflict interests: The authors declare no potential conflict of interest.
References
- Doehlemann, G.; Ökmen, B.; Zhu, W.; Sharon, A. Plant Pathogenic Fungi. Microbiol. Spectr. 2017, 5, 1–23. [Google Scholar] [CrossRef]
- Termorshuizen, A.J. Ecology of Fungal Plant Pathogens. Microbiol. Spect. 2016, 4, 1–11. [Google Scholar] [CrossRef] [PubMed]
- Fisher, M.C.; Gurr, S.J.; Cuomo, C.A.; Blehert, D.S.; Jin, H.; Stukenbrock, E.H.; Stajich, J.E.; Kahmann, R.; Boone, C.; Denning, D.W.; Gow, N.A.R.; Klein, B.S.; Kronstad, J.W.; Sheppard, D.C.; Taylor, J.W.; Wright, G.D.; Heitman, J.; Casadevall, A.; Cowen, L.E. Threats Posed by the Fungal Kingdom to Humans, Wildlife, and Agriculture. mBio 2020, 11, e00449–20. [Google Scholar] [CrossRef]
- Fisher, M.C.; Hawkins, N.J.; Sanglard, D.; Gurr, S.J. Worldwide emergence of resistance to antifungal drugs challenges human health and food security. Science 2018, 360, 739–742. [Google Scholar] [CrossRef]
- Hartman, G.L. Rupe, J.C.; Sikora, E.J.; Domier, L.L.; Davis, J.A.; Steffey, K.L. Compendium of soybean diseases and pests. Fifth edition. Disease compendium series., 5th ed.; The American Phytopathological Society: APS Press, St. Paul, Minnesota (U.S.A.), 2015; p. 201. [Google Scholar]
- Hosseini, B.; Voegele, R.T.; Link, T.I. Diagnosis of Soybean Diseases Caused by Fungal and Oomycete Pathogens: Existing Methods and New Developments. J. of Fungi 2023, 9, 587. [Google Scholar] [CrossRef]
- Yang, X.B.; Feng, F. Ranges and Diversity of Soybean Fungal Diseases in North America. Phytopathol. 2001, 91, 769–775. [Google Scholar] [CrossRef]
- Martins, P.M.M.; Merfa, M.V.; Takita, M.A.; De Souza, A.A. Persistence in Phytopathogenic Bacteria: Do We Know Enough? Front. Microbiol. 2018, 9, 1–14. [Google Scholar] [CrossRef] [PubMed]
- Sharma, I. Chapter 7 - Phytopathogenic fungi and their biocontrol applications. In Fungi Bio-Prospects in Sustainable Agriculture, Environment and Nano-Technology; Sharma, V.K., Shah, M.P., Parmar, S., Kumar, A., Eds.; Elsevier - Academic Press: Amsterdam, 2021; Volume 1, pp. 155–188. [Google Scholar] [CrossRef]
- Davies, C.R.; Wohlgemuth, F.; Young, T.; Violet, J.; Dickinson, M.; Sanders, J.W.; Vallieres, C.; Avery, S.V. Evolving challenges and strategies for fungal control in the food supply chain. Fungal Biol. Rev. 2021, 36, 15–26. [Google Scholar] [CrossRef]
- Cheam, D.; Nishiguchi, M.K. Organisms. In Encyclopedia of Biodiversity, 3rd ed.; Scheiner, S.M., Ed.; Elsevier: Oxford, 2024; Volume 6, pp. 242–252. [Google Scholar] [CrossRef]
- Wall, D.H.; Moore, J.C. Interactions Underground: Soil biodiversity, mutualism, and ecosystem processes. BioScience 1999, 49, 109–117. [Google Scholar] [CrossRef]
- Hutchings, M.I.; Palmer, T.; Harrington, D.J.; Sutcliffe, I.C. Lipoprotein biogenesis in Gram-positive bacteria: knowing when to hold ‘em, knowing when to fold ‘em. Trends Microbiol. 2009, 17, 13–21. [Google Scholar] [CrossRef]
- Hutchings, M.I.; Wilkinson, B. Insects and their antibiotic-producing bacteria. Microb. and Host. 2023, 1, e230008. [Google Scholar] [CrossRef]
- Stock, S.P.; Hazir, S. The bacterial symbionts of Entomopathogenic nematodes and their role in symbiosis and pathogenesis. J. of Invert. Pathol. 2025, 211, 108295. [Google Scholar] [CrossRef] [PubMed]
- Sajnaga, E.; Kazimierczak, W.; Karaś, M.A.; Jach, M.E. Exploring Xenorhabdus and Photorhabdus nematode symbionts in search of novel therapeutics. Molecules 2024, 29, 5151. [Google Scholar] [CrossRef] [PubMed]
- Forst, S.; Dowds, B.; Boemare, N.; Stackebrandt, E. Xenorhabdus and Photorhabdus spp.: bugs that kill bugs. Annu. Rev. Microbiol. 1997, 51, 47–72. [Google Scholar] [CrossRef] [PubMed]
- Koppenhöfer, A.M.; Shapiro-Ilan, D.I.; Hiltpold, I. Entomopathogenic Nematodes in Sustainable Food Production. Frontiers in Sust. F. Systems 2020, 4, 1–14. [Google Scholar] [CrossRef]
- Kaya, H.K. Natural enemies and other antagonists. In Entomopathogenic Nematology; Gaugler, R., Ed.; CAB International: Wallingford, UK, 2002; pp. 189–203. [Google Scholar] [CrossRef]
- Půža, V.; Machado, R.A.R. Systematics and phylogeny of the entomopathogenic nematobacterial complexes Steinernema–Xenorhabdus and Heterorhabditis–Photorhabdus. Zool. Letters 2024, 10, 13. [Google Scholar] [CrossRef]
- Bock, C.H.; Shapiro-Ilan, D.I.; Wedge, D.E.; Cantrell, C.L. Identification of the antifungal compound, trans-cinnamic acid, produced by Photorhabdus luminescens, a potential biopesticide against pecan scab. J. Pest. Sci. 2014, 87, 155–162. [Google Scholar] [CrossRef]
- Chacón-Orozco, J.G.; Bueno, C.J.; Shapiro-Ilan, D.I.; Hazir, S.; Leite, L.G.; Harakava, R. Antifungal activity of Xenorhabdus spp. and Photorhabdus spp. against the soybean pathogenic Sclerotinia sclerotiorum. Sci. Rep. 2020, 10, 20649. [Google Scholar] [CrossRef]
- Kgosiemang, J.L.; Ramakuwela, T.; Figlan, S.; Cochrane, N. Antifungal effect of metabolites from bacterial symbionts of entomopathogenic nematodes on Fusarium head blight of wheat. J. Fungi 2024, 10, 148. [Google Scholar] [CrossRef]
- Tu PW, Chiu JS, Lin C, Chien CC, Hsieh FC, Shih MC, Yang YL. Evaluation of the antifungal activities of Photorhabdus akhurstii and its secondary metabolites against phytopathogenic Colletotrichum gloeosporioides. J Fungi. 2022, 2022 8, 403. [Google Scholar] [CrossRef]
- Fang, X.; Zhang, M.; Tang, Q.; Wang, Y.; Zhang, X. Inhibitory effect of Xenorhabdus nematophila TB on plant pathogens Phytophthora capsici and Botrytis cinerea in vitro and in planta. Sci. Rep. 2014, 4, 4300. [Google Scholar] [CrossRef]
- Fang, X.L.; Li, Z.Z.; Wang, Y.H.; Zhang, X. In vitro and in vivo antimicrobial activity of Xenorhabdus bovienii YL002 against Phytophthora capsici and Botrytis cinerea. J. of Applied Microbiol. 2011, 111, 145–154. [Google Scholar] [CrossRef]
- Gülcü, B.; Altın, N. Control potency of Trans-cinnamic acid and antifungal metabolites of Xenorhabdus szentirmaii against Alternaria brassicicola. Dubited 2024, 12, 365–374. [Google Scholar] [CrossRef]
- Hazir, S.; Shapiro-Ilan, D.; Bock, C.; Leite, L. Thermo-stability, dose effects and shelf-life of antifungal metabolite-containing supernatants produced by Xenorhabdus szentirmaii. Eur J. of Plant Pathol. 2017, 150. [Google Scholar] [CrossRef]
- San-Blas, E.; Carrillo, Z.; Parra, Y. Effect of Xenorhabdus and Photorhabdus bacteria and their exudates on Moniliophthora roreri. Arch. of Phytopathol. and Plant Prot. 2012, 45, 1950–1967. [Google Scholar] [CrossRef]
- San-Blas, E.; Parra, Yennis. ; and Carrillo, Z. Effect of Xenorhabdus and Photorhabdus bacteria (Enterobacteriales: Enterobacteriaceae) and their exudates on the apical rotten fruit disease caused by Dothiorella sp. in guava (Psidium guajava). Arch. of Phytopathol. and Plant Prot. 2013, 46, 2294–2303. [Google Scholar] [CrossRef]
- Wang, Y.; Zhang, F.; Wang, C.; Guo, P.; Han, Y.; Zhang, Y.; Sun, B.; Shan, S.; Ruan, W.; Pan, J. Antifungal substances produced by Xenorhabdus bovienii and its Inhibition mechanism against Fusarium solani. Int. J. Mol. Sci. 2022, 23, 9040. [Google Scholar] [CrossRef] [PubMed]
- Shi, D.; An, R.; Zhang, W.; Zhang, G.; Yu, Z. Stilbene Derivatives from Photorhabdus temperata SN259 and their antifungal activities against phytopathogenic fungi. J. Agric. Food Chem. 2017, 65, 60–65. [Google Scholar] [CrossRef] [PubMed]
- Joyce, S.A.; Lango, L.; Clarke, D.J. The Regulation of Secondary Metabolism and Mutualism in the Insect Pathogenic Bacterium Photorhabdus luminescens. In: Laskin, A.I.; Sariaslani, S.; Gadd, G.M. editors. Adv. in Applied Microbiol. Acad. [CrossRef]
- Shi, Y.-M.; Hirschmann, M.; Shi, Y.-N.; Ahmed, S.; Abebew, D.; Tobias, N.J.; Grün, P.; Crames, J.J.; P¨oschel, L.; Kuttenlochner, W.; Richter, C.; Herrmann, J.; Müller, R.; Thanwisai, A.; Pidot, S.J.; Stinear, T.P.; Groll, M.; Kim, Y.; Bode, H.B. Global analysis of biosynthetic gene clusters reveals conserved and unique natural products in entomopathogenic nematode-symbiotic bacteria. Nat. Chem. 2022, 14, 701–712. [Google Scholar] [CrossRef]
- Houard, J.; Aumelas, A.; Noël, T.; Pages, S.; Givaudan, A.; Fitton-Ouhabi, V.; Villain-Guillot, P.; Gualtieri, M. Cabanillasin, a new antifungal metabolite, produced by entomopathogenic Xenorhabdus cabanillasii JM26. J Antibiot. 2013, 66, 617–620. [Google Scholar] [CrossRef]
- Parihar, R.D.; Dhiman, U.; Bhushan, A.; Gupta, P.K.; Gupta, P. Heterorhabditis and Photorhabdus symbiosis: A natural mine of bioactive compounds. Front. Microbiol. 2022, 13, 790339. [Google Scholar] [CrossRef]
- Ullah, I.; Khan, A.L.; Ali, L.; Khan, A.R.; Waqas, M.; Hussain, J.; Lee, I.-J.; Shin, J.-H. Benzaldehyde as an insecticidal, antimicrobial, and antioxidant compound produced by Photorhabdus temperata M1021. J. Microbiol. 2015, 53, 127–133. [Google Scholar] [CrossRef]
- Fischer-Le Saux, M.; Viallard, V.; Brunel, B.; Normand, P.; Boemare, N. E. Polyphasic classification of the genus Photorhabdus and proposal of new taxa: P. luminescens subsp. luminescens subsp. nov., P. luminescens subsp. akhurstii subsp. nov., P. luminescens subsp. laumondii supsp. nov., P. temperata sp. nov., P. temperata subsp. temperata subsp. nov., and P. asymbiotica sp. nov. Int. J. Syst. Bacteriol. 1999, 49, 1645–1656. [Google Scholar]
- Gulsen, S.H.; Tileklioglu, E.; Bode, E.; Cimen, H.; Ertabaklar, H.; Ulug, D.; Ertug, S.; Wenski, S.L.; Touray, M.; Hazir, C.; Bilecenoglu, D.K.; Yildiz, I.; Bode, H.B.; Hazir, S. Antiprotozoal activity of different Xenorhabdus and Photorhabdus bacterial secondary metabolites and identification of bioactive compounds using the easyPACId approach. Sci. Rep. 2022, 12, 10779. [Google Scholar] [CrossRef]
- Yuan, B. , Li, B., Shen, H., Duan, J., Jia, F., Maimaiti, Y., Li, Y., Li, G. Identification of fabclavine derivatives, Fcl-7 and Fcl-8, from Xenorhabdus budapestensis as major antifungal natural products against Rhizoctonia solani. J. Appl. Microbiol. 2023, 134, lxad190. [Google Scholar] [CrossRef]
- Li, B. , Yuan, B., Duan, J., Qin, Y., Shen, H., Ren, J., Francis, F., Chen, M., Li, G. Identification of Fcl-29 as an effective antifungal natural product against Fusarium graminearum and combinatorial engineering strategy for improving its yield. J. Agric. Food Chem. 2023, 71, 5554–5564. [Google Scholar] [CrossRef]
- Priya, S.S.; Deeikshana, T.; Haran, R; Shandeep, G. ; Pradeep, S; Sumathi, E. Biocontrol potential and characterization of cell-free supernatants from Xenorhabdus nematophila: A novel approach to control Tetranychus urticae. Crop Prot. 2025, 193, 107185. [Google Scholar] [CrossRef]
- Kamou, N. , Papafoti, A., Chatzaki, V., Kapranas, A. Exploring the effects of entomopathogenic nematode symbiotic bacteria and their cell free filtrates on the tomato leafminer Tuta absoluta and its predator Nesidiocoris tenuis. J. Invertebr. Pathol. 2024, 206, 108181. [Google Scholar] [CrossRef] [PubMed]
- Bode, E.; Heinrich, A.K.; Hirschmann, M.; Abebew, D.; Shi, Y.-N.; Vo, T.D.; Wesche, F.; Shi, Y.-M.; Grün, P.; Simonyi, S.; Keller, N.; Engel, Y.; Wenski, S.; Bennet, R.; Beyer, S.; Bischoff, I.; Buaya, A.; Brandt, S.; Cakmak, I.; Çimen, H.; Eckstein, S.; Frank, D.; Fürst, R.; Gand, M.; Geisslinger, G.; Hazir, S.; Henke, M.; Heermann, R.; Lecaudey, V.; Schäfer, W.; Schiffmann, S.; Schüffler, A.; Schwenk, R.; Skaljac, M.; Thines, E.; Thines, M.; Ulshöfer, T.; Vilcinskas, A.; Wichelhaus, T.A.; Bode, H.B. Promoter Activation in Δhfq Mutants as an Efficient Tool for Specialized Metabolite Production Enabling Direct Bioactivity Testing. Angew Chem. Int. Ed. Engl. 2019, 58, 18957–18963. [Google Scholar] [CrossRef] [PubMed]
- Vicente-Díez, I.; Moreira, X.; Pastor, V.; Vilanova, M.; Pou, A.; Campos-Herrera, R. Control of post-harvest gray mold (Botrytis cinerea) on grape (Vitis vinifera) and tomato (Solanum lycopersicum) using volatile organic compounds produced by Xenorhabdus nematophila and Photorhabdus laumondii subsp. laumondii. BioControl 2023, 68, 549–563. [Google Scholar] [CrossRef]
- Chen, G.; Dunphy, G.B.; Webster, J.M. Antifungal Activity of Two Xenorhabdus Species and Photorhabdus luminescens, Bacteria Associated with the Nematodes Steinernema Species and Heterorhabditis megidis. Biol. Control 1994, 4, 157–162. [Google Scholar] [CrossRef]
- Vanitha, L.; Kumari, M.; Jayappa, J.; Chandrashekar, S.C. Symbiotic bactéria, Xenorhabdus spp. of entomopathogenic nematodes: source of antifungal compounds against four plant pathogens. Asian J. of Bio Sc. 2020, 5, 174–177. [Google Scholar]
- Lalramchuani, M.; Lalramnghaki, H.C.; Vanlalsangi, R.; Lalhmingliani, E.; Vanramliana, Lalramliana. Characterization and screening of antifungal activity of bacteria associated with entomopathogenic nematodes from Mizoram, North-Eastern India. J. of Environ. Biol. 2020, 41, 942–950. [Google Scholar] [CrossRef]
- Sharma, K.; Walia, S.; Ganguli, S.; Kundu, A. Analytical Characterization of Secondary Metabolites from Indian Xenorhabdus Species the Symbiotic Bacteria of Entomopatathogenic Nematode (Steinernema spp.) as Antifungal Agent. Natl. Acad. Sci. Lett. 2016, 39, 175–180. [Google Scholar] [CrossRef]
- Reimer, D.; Nollmann, F.I.; Schultz, K.; Kaiser, M.; Bode, H.B. Xenortide Biosynthesis by Entomopathogenic Xenorhabdus nematophila. J. Nat. Prod. 2014, 77, 1976–1980. [Google Scholar] [CrossRef] [PubMed]
- Wenski, S.L.; Cimen, H.; Berghaus, N.; Fuchs, S.W.; Hazir, S.; Bode, H.B. Fabclavine diversity in Xenorhabdus bacteria. Beilstein J. Org. Chem. 2020, 16, 956–965. [Google Scholar] [CrossRef] [PubMed]
- Donmez Ozkan, H.; Cimen, H.; Ulug, D.; Wenski, S.; Yigit Ozer, S.; Telli, M.; Aydin, N.; Bode, H.B.; Hazir, S. Nematode-Associated Bacteria: Production of Antimicrobial Agent as a Presumptive Nominee for Curing Endodontic Infections Caused by Enterococcus faecalis. Front. Microbiol. 2019, 10, 2672. [Google Scholar] [CrossRef]
- Zhang, S.; Han, Y.; Wang, L.; Han, J.; Yan, Z.; Wang, Y.; Wang, Y. Antifungal Activity and Mechanism of Xenocoumacin 1, a Natural Product from Xenorhabdus nematophila against Sclerotinia sclerotiorum. J. of Fungi 2024, 10, 175. [Google Scholar] [CrossRef] [PubMed]
- Zumbrunn, C.; Krüsi, D.; Stamm, C.; Caspers, P.; Ritz, D.; Rueedi, G. Synthesis and Structure-Activity Relationship of Xenocoumacin 1 and Analogues as Inhibitors of Ribosomal Protein Synthesis. ChemMedChem 2021, 16, 891–897. [Google Scholar] [CrossRef]
- Yang, X.; Qiu, D.; Yang, H.; Liu, Z.; Zeng, H.; Yuan, J. Antifungal activity of xenocoumacin 1 from Xenorhabdus nematophilus var. pekingensis against Phytophthora infestans. World J. Microb. Biotech. 2011, 27, 523–528. [Google Scholar] [CrossRef]
- Vicente-Díez, I.; Duenas-Hernani, J; Campos-Herrera, R. Antifungal activity of Xenorhabdus and Photorhabdus against aerial and soilborne grapevine pathogens: varying efficiencies and non-target effects. Biol. Control 2025, 205, 105759. [Google Scholar] [CrossRef]
- Deeikshana, T. , Poorniammal, R., Shandeep, S.G., Vijay, S., Prabhu, S. Exploring nematicidal biomolecules from Xenorhabdus nematophila as a novel source for Meloidogyne incognita management. Toxicon 2024, 250, 108101. [Google Scholar] [CrossRef]
- Kim, J.H.; Lee, B.M.; Lee, H.C.; Choi, I.S.; Koo, K.B.; Son, K.H. Antagonistic efficacy of symbiotic bacterium Xenorhabdus sp. SCG against Meloidogyne spp. J. Microbiol. Biotechnol. 2024, 34, 1627–1635. [Google Scholar] [CrossRef]
- Nermuť, J.; Hristov, Y.; Podrábská, V.; Kraml, A.; Skoková Habuštová, O.; Konopická, J.; Doležal, P.; Půža, V. Potential of cell-free supernatants of Xenorhabdus and Photorhabdus bacteria for the control of virus-transmitting aphids (Myzus persicae). J. Appl. Microbiol. 2025, 136, lxaf150. [Google Scholar] [CrossRef]
- Furgani, G.; Boszormenyi, E.; Fodor, A.; Fodor, A.M.; Forst, S.; Hogan, J.; Katona, Z.; Klein, M.G.; Stackebrandt, E.; Szentirmai, A.; Sztaricskai, F.; Wolf, S. Xenorhabdus antibiotics: a comparative analysis and potential utility for controlling mastitis caused by bacteria. J. Appl. Microbiol. 2008, 104, 745–758. [Google Scholar] [CrossRef] [PubMed]
Figure 1.
Activities of cell free supernatants at concentrations of 5%, 10%, and 20% on phytopathogenic fungi. Data on mycelial growth area presented as mean mycelial inhibition ± standard error. The effects of each concentration were analyzed using ANOVA with Tukey’s test (p<0.05). Different letters above the bars represent statistical difference at tested concentrations. A. Sclerotinia sclerotiorum. B. Botrytis cinerea. C. Macrophomina phaseolina. D. Fusarium oxysporum. Abbreviations: X. nem: Xenorhabdus nematophila, P. kay: Photorhabdus kayaii, X. dou: Xenorhabdus doucetiae, X. sze DSM: Xenorhabdus szentirmaii DSM 16338, X. sze PAM: Xenorhabdus szentirmaii PAM 25.
Figure 1.
Activities of cell free supernatants at concentrations of 5%, 10%, and 20% on phytopathogenic fungi. Data on mycelial growth area presented as mean mycelial inhibition ± standard error. The effects of each concentration were analyzed using ANOVA with Tukey’s test (p<0.05). Different letters above the bars represent statistical difference at tested concentrations. A. Sclerotinia sclerotiorum. B. Botrytis cinerea. C. Macrophomina phaseolina. D. Fusarium oxysporum. Abbreviations: X. nem: Xenorhabdus nematophila, P. kay: Photorhabdus kayaii, X. dou: Xenorhabdus doucetiae, X. sze DSM: Xenorhabdus szentirmaii DSM 16338, X. sze PAM: Xenorhabdus szentirmaii PAM 25.
Figure 2.
Inhibition of mycelial growth of the fungal pathogen Sclerotinia sclerotiorum at concentrations of 5%, 10%, and 20% of the respective bacterial cell free supernatant.
Figure 2.
Inhibition of mycelial growth of the fungal pathogen Sclerotinia sclerotiorum at concentrations of 5%, 10%, and 20% of the respective bacterial cell free supernatant.
Figure 3.
Inhibition of mycelial growth of the fungal pathogen Botrytis cineria at concentrations of 5%, 10%, and 20% of the respective bacterial cell free supernatant.
Figure 3.
Inhibition of mycelial growth of the fungal pathogen Botrytis cineria at concentrations of 5%, 10%, and 20% of the respective bacterial cell free supernatant.
Figure 4.
Inhibition of mycelial growth of the fungal pathogen Macrophomina phaseolina at concentrations of 5%, 10%, and 20% of the respective bacterial cell free supernatant.
Figure 4.
Inhibition of mycelial growth of the fungal pathogen Macrophomina phaseolina at concentrations of 5%, 10%, and 20% of the respective bacterial cell free supernatant.
Figure 5.
Inhibition of mycelial growth of the fungal pathogen Fusarium oxysporum at concentrations of 5%, 10%, and 20% of the respective bacterial cell free supernatant.
Figure 5.
Inhibition of mycelial growth of the fungal pathogen Fusarium oxysporum at concentrations of 5%, 10%, and 20% of the respective bacterial cell free supernatant.
Figure 6.
Activities of supernatants from each secondary metabolite produced by the respective easyPACId strain Xenorhabdus szentirmaii Δhfq and Δpptase mutants on phytopathogenic fungi. Negative control: LB agar. Positive control: X. szentirmaii DSM 16338 (Wild Type) isolate. Data on mycelial growth area presented as mean mycelial inhibition ± standard error. The effects of each concentration were analyzed using ANOVA with Tukey’s test (p<0.05). Different letters above the bars represent statistical difference at tested concentrations.
Figure 6.
Activities of supernatants from each secondary metabolite produced by the respective easyPACId strain Xenorhabdus szentirmaii Δhfq and Δpptase mutants on phytopathogenic fungi. Negative control: LB agar. Positive control: X. szentirmaii DSM 16338 (Wild Type) isolate. Data on mycelial growth area presented as mean mycelial inhibition ± standard error. The effects of each concentration were analyzed using ANOVA with Tukey’s test (p<0.05). Different letters above the bars represent statistical difference at tested concentrations.
Figure 7.
Activities of supernatants enriched with selected natural products produced by the respective easyPACId strains of Xenorhabdus doucetiae Δhfq on phytopathogenic fungi. Negative control: LB agar. A. Sclerotinia sclerotiorum, B. Botrytis cinerea, C. Macrophomina phaseolina, D. Fusarium oxysporum. Data on mycelial growth area presented as mean mycelial inhibition ± standard error. The effects of each concentration were analyzed using ANOVA with Tukey’s test (p<0.05). Different letters above the bars represent statistical difference at tested concentrations.
Figure 7.
Activities of supernatants enriched with selected natural products produced by the respective easyPACId strains of Xenorhabdus doucetiae Δhfq on phytopathogenic fungi. Negative control: LB agar. A. Sclerotinia sclerotiorum, B. Botrytis cinerea, C. Macrophomina phaseolina, D. Fusarium oxysporum. Data on mycelial growth area presented as mean mycelial inhibition ± standard error. The effects of each concentration were analyzed using ANOVA with Tukey’s test (p<0.05). Different letters above the bars represent statistical difference at tested concentrations.
Figure 8.
Percentage of soybean seed germination treated with Xenorhabdus szentirmaii PAM 25 culture broth and cell free supernatant (CFS), diluted at different concentration, followed by inoculation with the fungus Sclerotinia sclerotiorum. Abbreviations: SM: Secondary metabolites. Identical lowercase letters indicate no significant differences between treatments, according to Tukey’s test at a 5% significance level. CV (%) = 8.5.
Figure 8.
Percentage of soybean seed germination treated with Xenorhabdus szentirmaii PAM 25 culture broth and cell free supernatant (CFS), diluted at different concentration, followed by inoculation with the fungus Sclerotinia sclerotiorum. Abbreviations: SM: Secondary metabolites. Identical lowercase letters indicate no significant differences between treatments, according to Tukey’s test at a 5% significance level. CV (%) = 8.5.
Table 1.
Percentage of mycelial growth inhibition of Sclerotinia sclerotiorum tested with supernatants of Xenorhabdus szentirmaii PAM 25 stored at different temperatures for up to 360 days.
Table 1.
Percentage of mycelial growth inhibition of Sclerotinia sclerotiorum tested with supernatants of Xenorhabdus szentirmaii PAM 25 stored at different temperatures for up to 360 days.
Table 2.
Δhfq mutants of Xenorhabdus szentirmaii and X. doucetiae generated using the easyPACid method and their synthesized molecules
Table 2.
Δhfq mutants of Xenorhabdus szentirmaii and X. doucetiae generated using the easyPACid method and their synthesized molecules
|
Disclaimer/Publisher’s Note: The statements, opinions and data contained in all publications are solely those of the individual author(s) and contributor(s) and not of MDPI and/or the editor(s). MDPI and/or the editor(s) disclaim responsibility for any injury to people or property resulting from any ideas, methods, instructions or products referred to in the content. |
© 2025 by the authors. Licensee MDPI, Basel, Switzerland. This article is an open access article distributed under the terms and conditions of the Creative Commons Attribution (CC BY) license (http://creativecommons.org/licenses/by/4.0/).